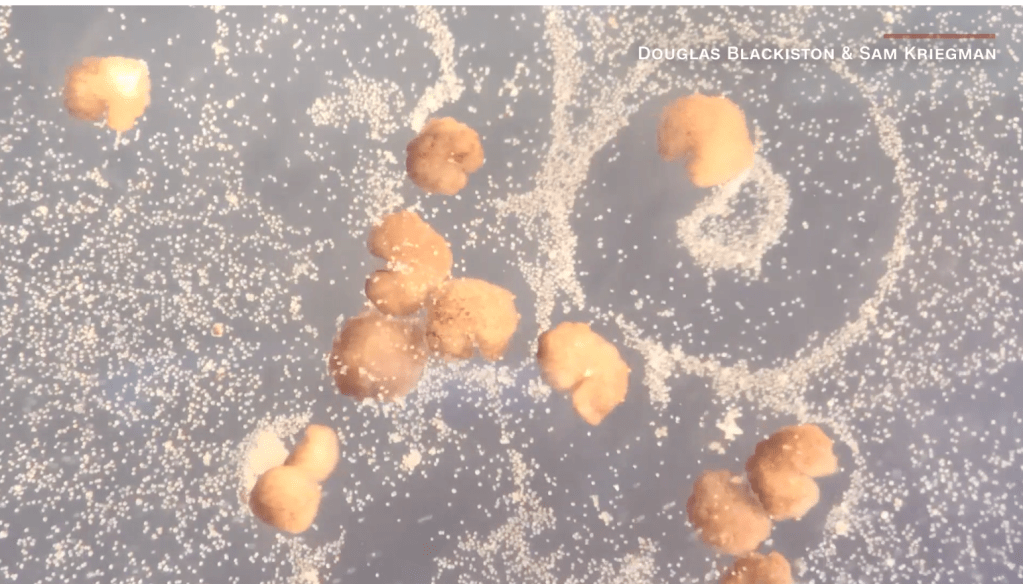

World’s first living robots can now reproduce, scientists say (click for story)
I had never really conceived of xenobots, or nanobots, but they already exist, and now there’s this. It wasn’t quite how I imagined it. It’s no less incredible and it makes perfect sense in a purely scientific sense. They’ve done it though, these scientists. They’ve gone and done it.
“Most people think of robots as made of metals and ceramics but it’s not so much what a robot is made from but what it does, which is act on its own on behalf of people,” said Josh Bongard, a computer science professor and robotics expert at the University of Vermont and lead author of the study.
On behalf of people…
And I do believe that this is the key phrase in all of this. We conceive of manmade life as an entity that will act on its own on behalf of the people who create it. And of course at some point if we can make it look more like people so there is a closer to seamless integration with our day to day lives. But I’m getting ahead of myself here. We are still a long way from a humanoid form, even if this is in and of itself a “miracle” of science. Still, this is what the origin of life must have looked like also. The scientists recreated the conditions by which everything else was created. The article doesn’t even hint at that, but it’s there. How many generations will it be before the xenobots mutate and begin to look entirely different than they looked when this article was written? A little food for thought…
Still going back to the line, on behalf of people. I’d mentioned in this space ages ago that our intentions for the highest levels of science were base and primitive. How do robots manifest in our imagination? We weaponize them, fuck them, enslave them, or all of the above. But why should we aspire to do more with manmade life that we do for organic life?
Weaponize. Fuck. Enslave.
All of the above.
Sorry, it’s just fascinated me for a long time and I’ve gotten far beyond the point of the article itself. There are many steps between this jumping off point and what’s still the subject of science fiction. It’s a major jump off in the right direction though, and that’s certainly not to say morally right. I mean right as in expected.
Just as expected.
